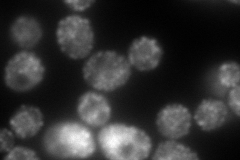
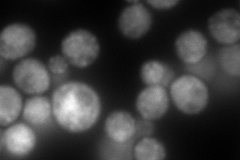

View description
Component of both the Nup84 nuclear pore sub-complex and the Sec13p-Sec31p complex of the COPII vesicle coat, required for vesicle formation in ER to Golgi transport and nuclear pore complex organization
Localization:
Intensity:
Fold change:
Significance:
-
C’ GFP library in SD

punctate144.07 -
N' NOP1pr-GFP in SD
ER,punctate212.415 -
N' TEF2pr-mCherry in SD
ER,punctate316.926 -
N' NATIVEpr-GFP in SD

ER,punctate85.2629 -
N' TEF2pr-VC and Cyto-VN in SD

#N/A0 -
C’ GFP library in SD+DTT

punctate207.651.44Yes -
C’ GFP library in SD+H2O2

punctate131.950.91No -
C’ GFP library in Starvation Media

punctate210.121.45Yes -
C’ GFP library on the background of Pup2-DaMP

punctate -
C’ GFP library on the background of CCT mutant

punctate132.820.921838No
